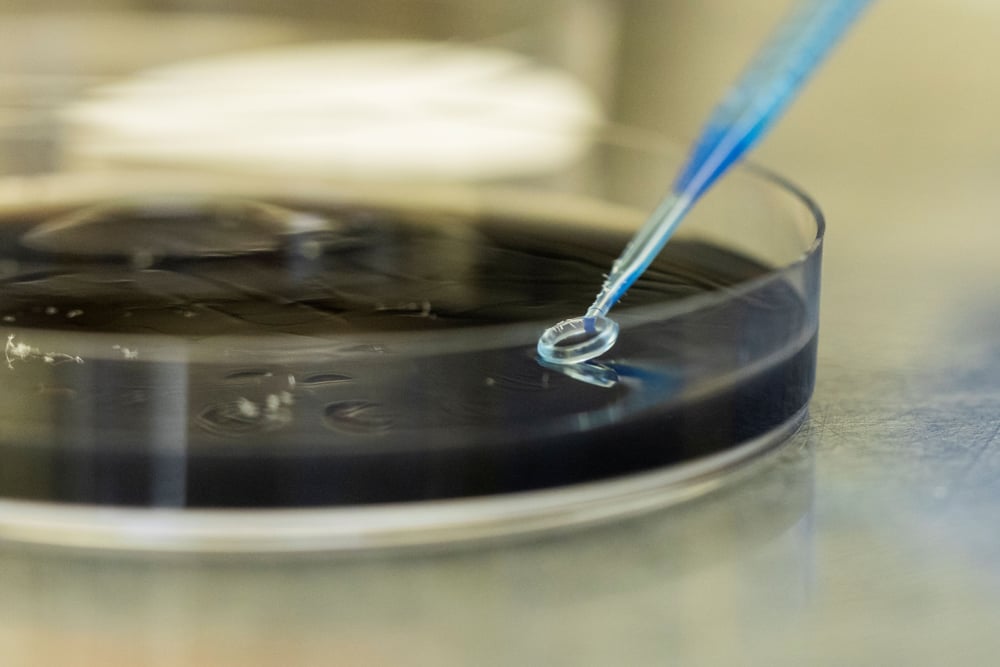

Mientras la sequía y el calor extremo amenazan la agricultura en Estados Unidos, investigadores de la University of Florida buscan soluciones más allá del planeta: enviarán semillas a la Estación Espacial Internacional (EEI) este jueves 31 de julio de 2025, con el fin de estudiar cómo la microgravedad y el entorno espacial afectan su genética y resiliencia.
Cuatro tipos de semillas viajarán con SpaceX
El profesor Wagner Vendrame, del departamento de horticultura ambiental del UF/IFAS, lidera el proyecto. Las semillas de fresa (de la región de la Bahía de Tampa), dos tipos de orquídeas nativas de Florida y un tipo de césped bahía serán transportadas a bordo de un cohete Falcon 9 de SpaceX, desde Cabo Cañaveral.

Wagner Vendrame, profesor del departamento de horticultura ambiental de UF/IFAS, sostiene semillas que se plantarán en la Tierra como versión de control de las que serán enviadas esta semana a la Estación Espacial Internacional. Fotografía cortesía de Tyler Jones, UF/IFAS.
Estas permanecerán sin intervención humana durante una semana en la EEI, antes de regresar a la Tierra para su germinación y análisis genético.
Objetivo: cultivos adaptados a condiciones extremas
El propósito del experimento es identificar cambios genéticos inducidos por el entorno espacial que puedan aprovecharse para crear plantas más resistentes al estrés ambiental en la Tierra, como sequías, olas de calor o heladas intensas.
“El espacio representa el entorno más estresante para las plantas. Estudiarlo nos permite simular y prepararnos para condiciones extremas similares en la Tierra”, explicó Vendrame.
Wagner Vendrame, profesor del departamento de horticultura ambiental de UF/IFAS, sostiene semillas que se plantarán en la Tierra como versión de control de las que serán enviadas esta semana a la Estación Espacial Internacional. Fotografía cortesía de Tyler Jones, UF/IFAS.
Parte de un esfuerzo global por la agricultura espacial
Este experimento forma parte de una iniciativa internacional liderada por la empresa Jaguar Space, en colaboración con EMBRAPA (la agencia agrícola de Brasil), y científicos de países como Argentina, Nigeria y Pakistán. Todos enviarán muestras vegetales como parte de la misma misión internacional de agricultura espacial.
Compararán los cambios con plantas cultivadas en la Tierra
Las semillas recuperadas se compararán con otras de las mismas especies cultivadas en el laboratorio terrestre de Vendrame. Así, los investigadores podrán determinar cómo influyen la microgravedad y el reingreso atmosférico en el desarrollo genético de las plantas.
UF ya tiene experiencia en este campo: su Laboratorio de Plantas Espaciales ha enviado anteriormente Arabidopsis thaliana (berro oreja de ratón) al espacio, detectando alteraciones genéticas significativas.

Wagner Vendrame, profesor del departamento de horticultura ambiental de UF/IFAS, sostiene semillas que se plantarán en la Tierra como versión de control de las que serán enviadas esta semana a la Estación Espacial Internacional. Fotografía cortesía de Tyler Jones, UF/IFAS.
Un paso hacia la producción de alimentos en Marte y la Luna
Además de sus aplicaciones en la Tierra, el proyecto busca sentar las bases para producir alimentos, generar oxígeno y sostener misiones espaciales de larga duración, esenciales para futuras colonias humanas en la Luna o Marte.
Este avance en biotecnología vegetal podría marcar un antes y un después tanto para la agricultura resiliente al clima como para la exploración espacial sostenida.
